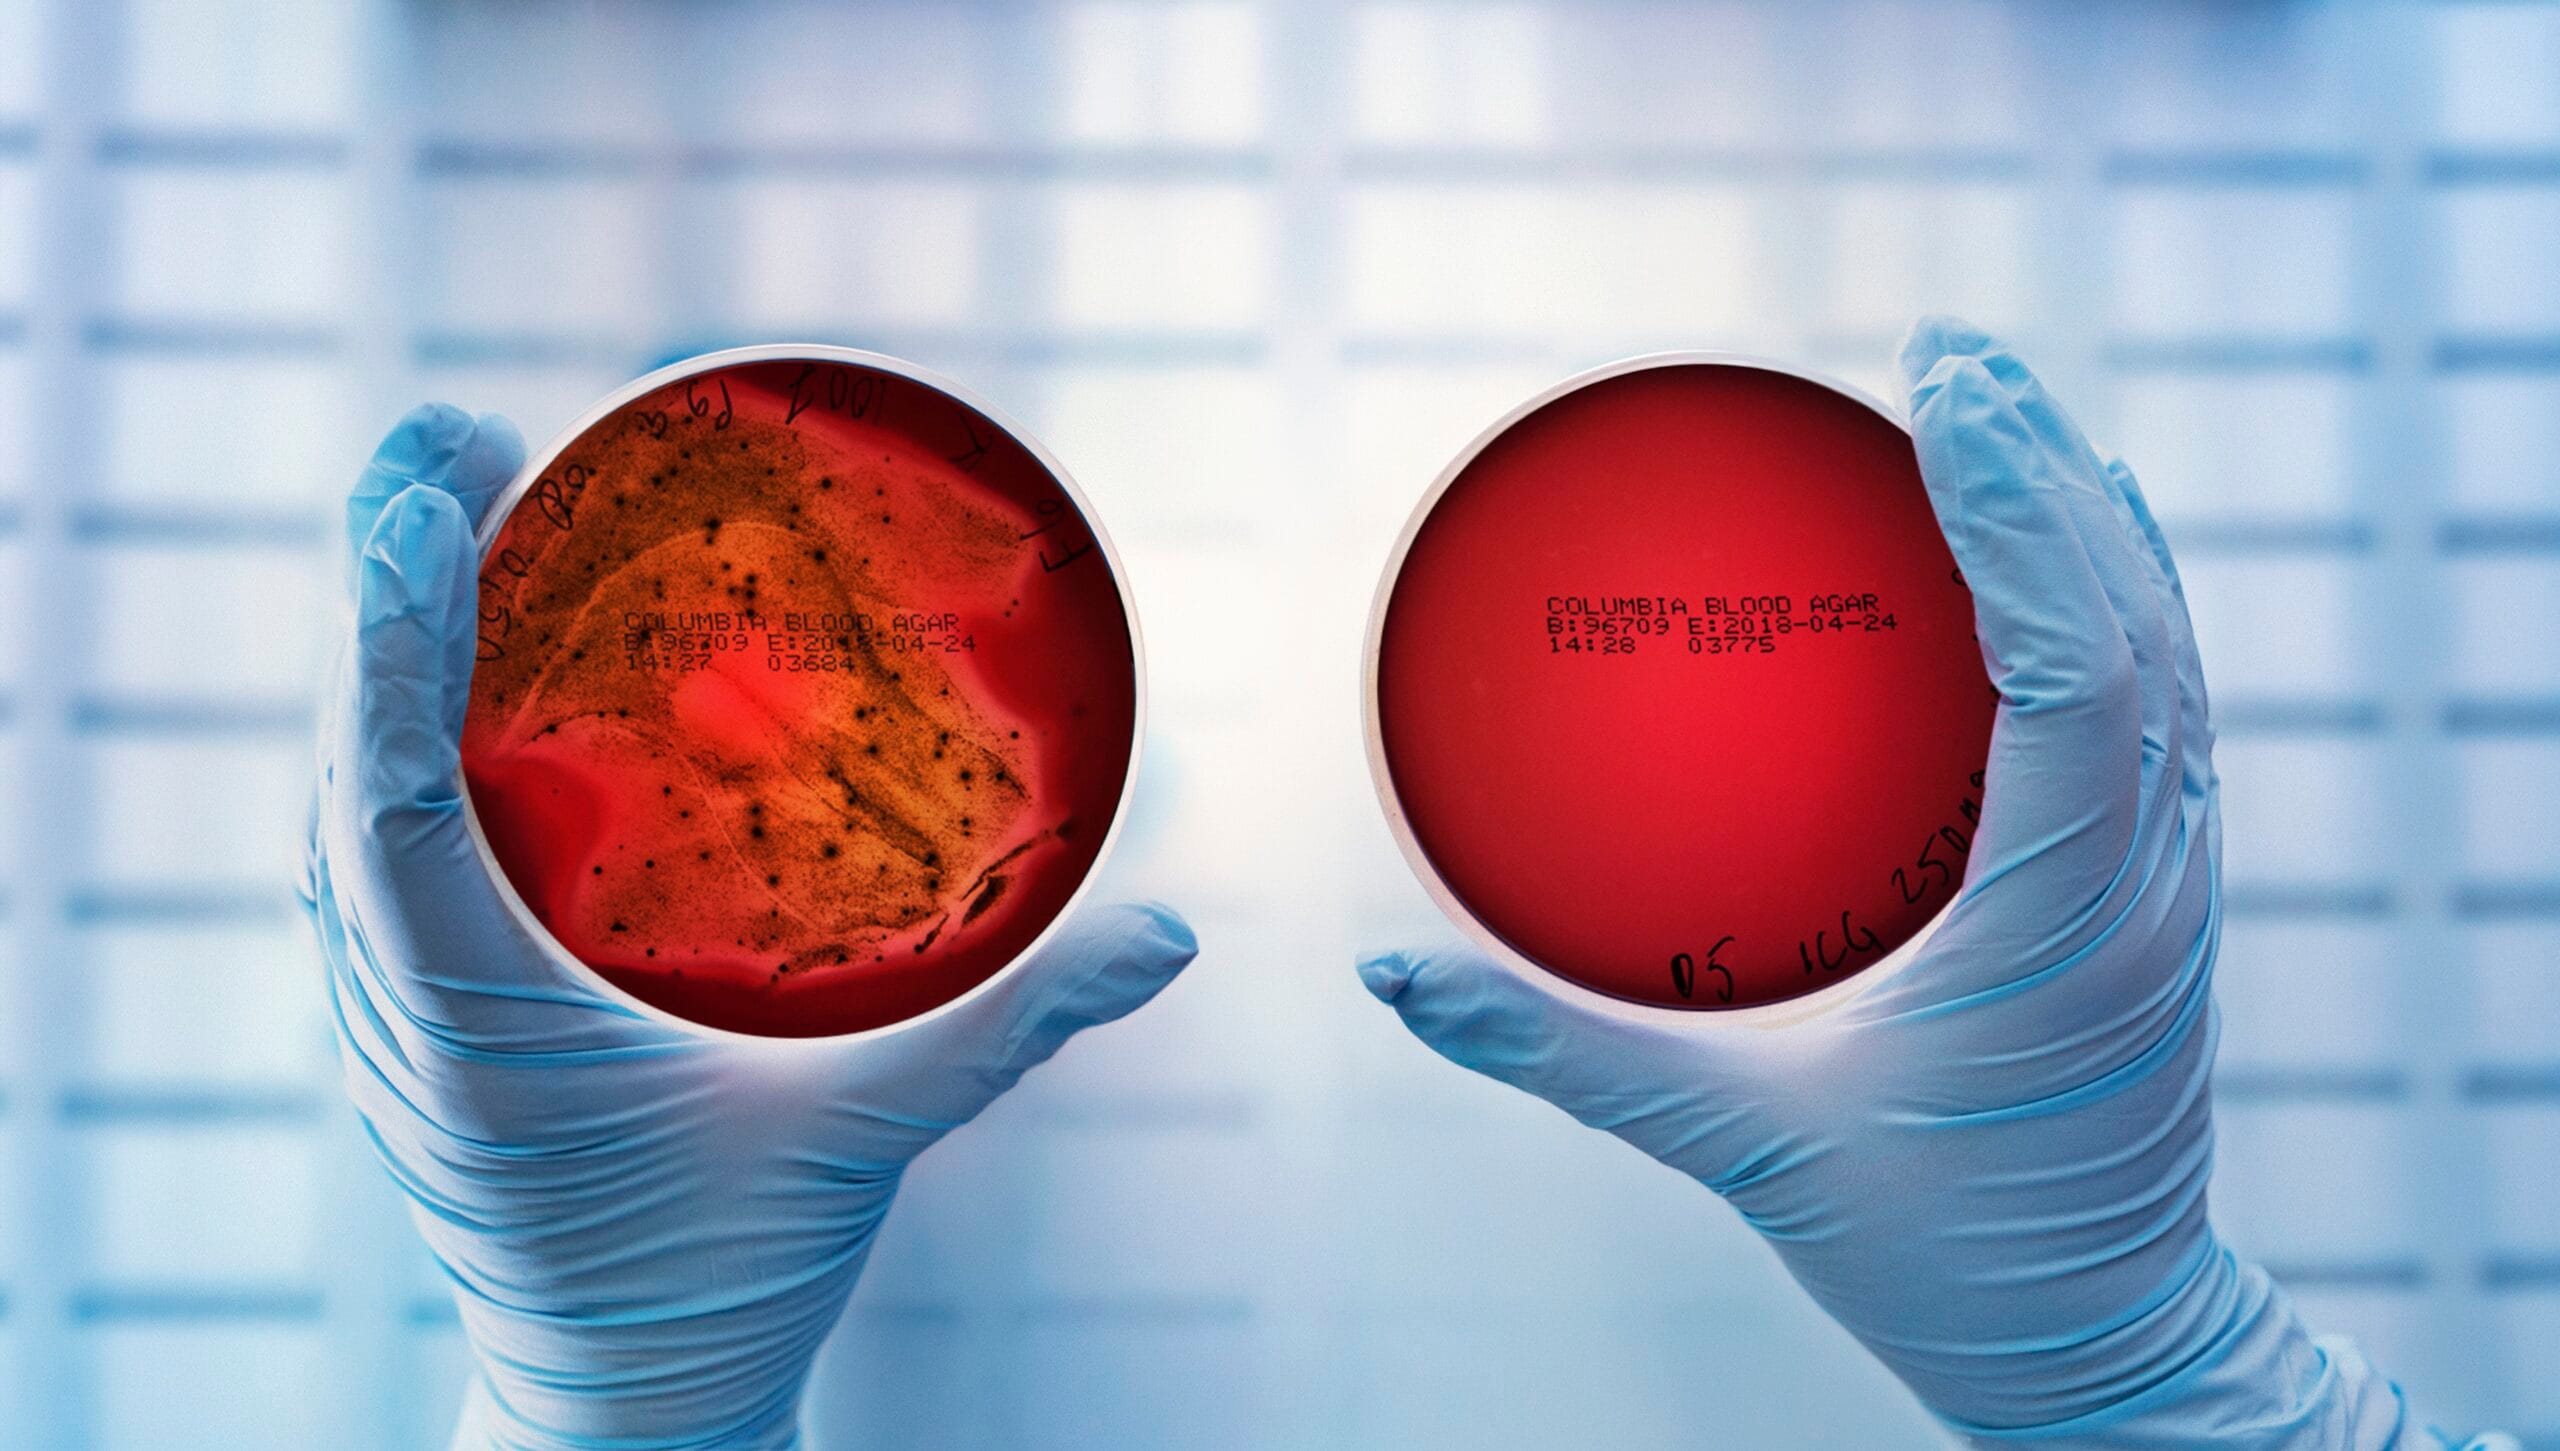
p. gingivalis untreated vs. lumoral treated

CE Webinar Basic Information:
Each one-hour virtual webinar moderated by MedMark Media is equivalent to one continuing education (CE) credit. Credit is available to all who register for the webinar and successfully complete a ten-question quiz through our publication’s online system.
Registrants can attend the webinar live at the specified date and time by using the GoToWebinar join link provided by email from any device with an internet connection. Using a laptop or desktop computer is recommended for best viewing the presentation. If you are using a mobile phone or tablet, we recommend using the GoToWebinar app instead of the web browser to improve ease of use for the webinar’s platform. Registrants will also have access to watch the replay at their own convenience through a link emailed to them within 24 hours of the specified live date and time which is hosted on our publication’s website.
If registrants would like to ask a question or receive further clarification, they can type their questions or comments in the question box of the webinar system. The moderator reminds the attendees multiple times before and after the presentation to use the question box. Questions are addressed at the end of the presentation for at least ten minutes. If any questions come in that are not able to be answered live in the time available, we give the question along with the registrant’s email address to the presenter for them to follow up directly.
Registrants will have to either sign in (previous webinar attendee) or sign up (first-time webinar attendee) for our CE quiz system on our publication’s website. Registrants of all CE webinars are allowed this account free of charge. The ten-question quiz is linked on the replay page below the video as well as available directly through the CE dashboard once the registrant is logged in.
Once the quiz is successfully completed, there is a button to download a PDF of the certificate. A copy of the CE certificate is also emailed to the address on file for the CE account. To ensure the deliverability of emails about CE credits, please:
- Check the spam/junk folder in your email account for the email.
- Set subscriptions@endopracticeus.com in your email platform.
If the registrant is having trouble accessing either the live webinar, replay, CE quiz or certificate we are available to help by email, chat, and phone. We can provide simple steps with screenshots on how to navigate to and complete the Webinar CE quizzes.
Legal disclaimer: Webinar expires 2 years from the live date. The CE provider uses reasonable care in selecting and providing accurate content. The CE provided, however, does not independently verify the content or materials. Any opinions expressed in the materials is those of the presenter and not the CE provider. The instructional materials are intended to supplement but are not a substitute for the knowledge, skills, expertise, and judgment of a trained healthcare professional.